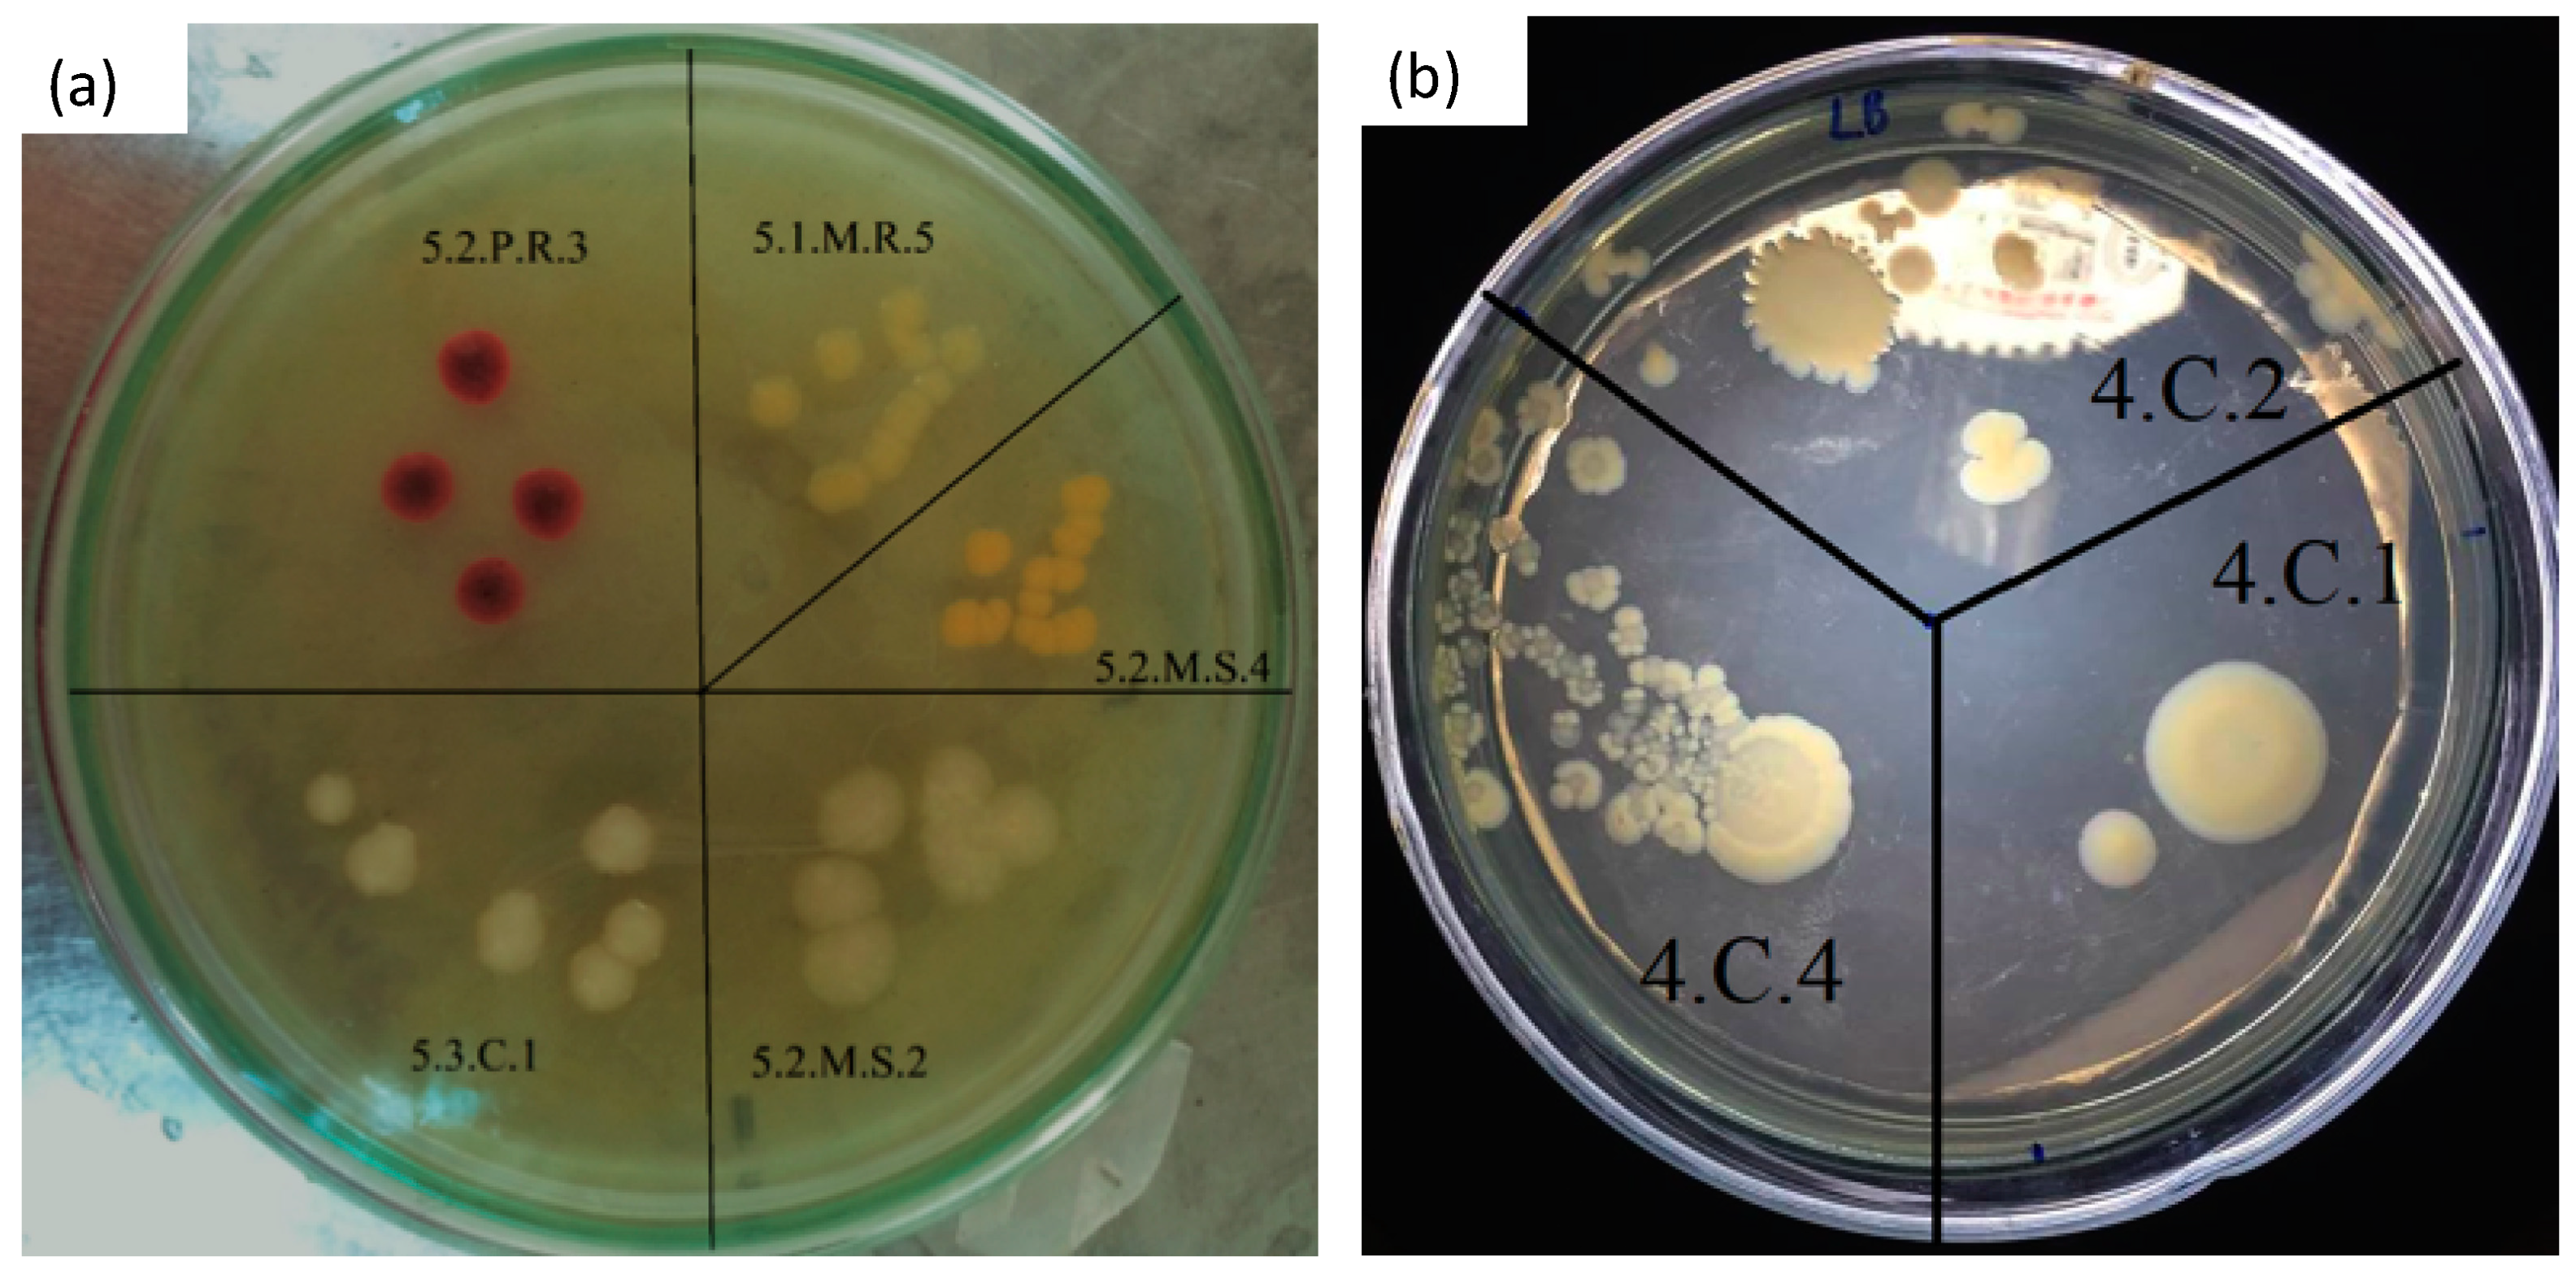
Sustainability 12 04758 g007 Sustainability 12 04758 g007

Loofah Sponges as Bio-Carriers in a Pilot-Scale Integrated Fixed-Film Activated Sludge System for Municipal Wastewater Treatment
Abstract
1. Introduction
2. Materials and Methods
2.1. Preparation and Modification of Loofah Sponges
2.2. IFAS Pilot-Scale Experiment
2.3. Analytical Method
3. Results and Discussion
3.1. Characterization of Loofah Sponges before and after Modification
3.2. Evaluation of Durability of Loofah Sponges in Water
3.3. IFAS Removal of Organic Compounds
3.4. Removal of Nitrogen Compounds
3.5. Microbial Evaluation
- (i)
- Kluyvera cryocrescens is Gram-negative, a member of Entertobacteriaceae, which has been found in sewage, milk wastewater, hospital wastewater [36]. Klebsiella aerogenes which is also in the Entertobacteriaceae family, is Gram-negative bacteria that is widely distributed in water, air, soil, can be isolated from sediment of polluted rivers [37].
- (ii)
- (iii)
- Bacillus tropicus is a Gram-positive bacillus, belonging to Firmicutes, Bacilli, Bacillales, Bacillaceae. They are aerobic microorganisms, best grown in aerobic conditions, in the optimal temperature of 15–32 °C. They have been used in wastewater treatment systems due to their ability to clean up contaminated components with low oxygen content and decompose organic matter in high concentrations in a short time [40].
- (iv)
- Aeromonas hydrophila is a Gram-negative bacterium, rod-shaped, belonging to Proteobacteria, Gammaproteobacteria, Aeromonadales, Aeromonadaceae. This is the most common species of the genus Aeromonas, which can live in both aerobic and anaerobic conditions. This strain is predominately found in treatment ponds [41,42] or domestic wastewater [43].
- (v)
- Enterobacter mori and Enterobacter cloacae are Gram-negative, arbitrary anaerobic, rod-shaped bacteria of the same branch of Proteobacteria, Gammaproteobacteria, Enterobacteriales, Enterobacteriaceae. They are capable of creating catalase but are not able to make oxidase [44]. They were reported to be good at removing heavy metals from wastewater [45].
- (vi)
- Pseudomonas turukhanskensis are Gram-negative bacteria of Proteobacteria, Gamaproteobacteria, Pseudomonadales, Pseudomonadaceaes. They are able to create oxidase and catalase. This strain often occurs in oily wastewaters, in particular at a temperature below 35 °C and pH 11 [46].
4. Conclusions
Author Contributions
Funding
Acknowledgments
Conflicts of Interest
References
- Borkar, R.; Gulhane, M.; Kotangale, A. Moving bed biofilm reactor–a new perspective in wastewater treatment. IOSR J. Environ. Sci. Toxicol. Food Technol. 2013, 6, 15–21. [Google Scholar]
- McQuarrie, J.P.; Boltz, J.P. Moving Bed Biofilm Reactor Technology: Process Applications, Design, and Performance. Water Environ. Res. 2011, 83, 560–575. [Google Scholar] [CrossRef] [PubMed]
- Ødegaard, H.; Rusten, B.; Westrum, T. A new moving bed biofilm reactor-applications and results. Water Sci. Technol. 1994, 29, 157. [Google Scholar] [CrossRef]
- Rusten, B.; McCoy, M.; Proctor, R.; Siljudalen, J.G. The innovative moving bed biofilm reactor/solids contact reaeration process for secondary treatment of municipal wastewater. Water Environ. Res. 1998, 70, 1083–1089. [Google Scholar] [CrossRef]
- Hoseinzadeh, E.; Rezaee, A.; Hossini, H. Biological Nitrogen Removal in Moving Bed Biofilm Reactor Using Ibuprofen as Carbon Source. Water Air Soil Pollut. 2016, 227, 46. [Google Scholar] [CrossRef]
- Bassin, J.P.; Dezotti, M.; Sant’Anna, G.L., Jr. Nitrification of industrial and domestic saline wastewaters in moving bed biofilm reactor and sequencing batch reactor. J. Hazard. Mater 2011, 185, 242–248. [Google Scholar] [CrossRef] [PubMed]
- Metcalf, E.; Abu-Orf, M.; Bowden, G.; Burton, F.L.; Pfrang, W.; Stensel, H.D.; Tchobanoglous, G.; Tsuchihashi, R. Wastewater Engineering: Treatment and Resource Recovery; McGraw Hill Education: New York, NY, USA, 2014. [Google Scholar]
- Chu, L.; Wang, J. Comparison of polyurethane foam and biodegradable polymer as carriers in moving bed biofilm reactor for treating wastewater with a low C/N ratio. Chemosphere 2011, 83, 63–68. [Google Scholar] [CrossRef] [PubMed]
- Droste, R.L.; Gehr, R.L. Theory and Practice of Water and Wastewater Treatment; John Wiley and Sons: Hoboken, NJ, USA, 2018. [Google Scholar]
- Liu, J.; Zhou, J.; Xu, N.; He, A.; Xin, F.; Ma, J.; Fang, Y.; Zhang, W.; Liu, S.; Jiang, M. Performance evaluation of a lab-scale moving bed biofilm reactor (MBBR) using polyethylene as support material in the treatment of wastewater contaminated with terephthalic acid. Chemosphere 2019, 227, 117–123. [Google Scholar] [CrossRef] [PubMed]
- Zhang, X.; Chen, X.; Zhang, C.; Wen, H.; Guo, W.; Ngo, H.H. Effect of filling fraction on the performance of sponge-based moving bed biofilm reactor. Bioresour. Technol. 2016, 219, 762–767. [Google Scholar] [CrossRef] [PubMed]
- Accinelli, C.; Saccà, M.L.; Mencarelli, M.; Vicari, A. Application of bioplastic moving bed biofilm carriers for the removal of synthetic pollutants from wastewater. Bioresour. Technol. 2012, 120, 180–186. [Google Scholar] [CrossRef] [PubMed]
- Borges, M.E.; Sierra, M.; Cuevas, E.; García, R.D.; Esparza, P. Photocatalysis with solar energy: Sunlight-responsive photocatalyst based on TiO2 loaded on a natural material for wastewater treatment. Sol. Energy 2016, 135, 527–535. [Google Scholar] [CrossRef]
- Wang, S.; Peng, Y. Natural zeolites as effective adsorbents in water and wastewater treatment. Chem. Eng. J. 2010, 156, 11–24. [Google Scholar] [CrossRef]
- Cruz-Morató, C.; Lucas, D.; Llorca, M.; Rodriguez-Mozaz, S.; Gorga, M.; Petrovic, M.; Barceló, D.; Vicent, T.; Sarrà, M.; Marco-Urrea, E. Hospital wastewater treatment by fungal bioreactor: Removal efficiency for pharmaceuticals and endocrine disruptor compounds. Sci. Total Environ. 2014, 493, 365–376. [Google Scholar] [CrossRef] [PubMed]
- Zhao, Y.; Cao, D.; Liu, L.; Jin, W. Municipal Wastewater Treatment by Moving-Bed-Biofilm Reactor with Diatomaceous Earth as Carriers. Water Environ. Res. 2006, 78, 392–396. [Google Scholar] [CrossRef] [PubMed]
- Bhuptawat, H.; Folkard, G.; Chaudhari, S. Innovative physico-chemical treatment of wastewater incorporating Moringa oleifera seed coagulant. J. Hazard. Mater. 2007, 142, 477–482. [Google Scholar] [CrossRef] [PubMed]
- Laidani, Y.; Hanini, S.; Henini, G. Use of fiber Luffa cylindrica for waters traitement charged in copper. Study of the possibility of its regeneration by desorption chemical. Energy Procedia 2011, 6, 381–388. [Google Scholar] [CrossRef]
- Henini, G.; Laidani, Y.; Souahi, F.; Hanini, S. Study of static adsorption system phenol/Luffa cylindrica fiber for industrial treatment of wastewater. Energy Procedia 2012, 18, 395–403. [Google Scholar] [CrossRef]
- Li, S.; Liu, F.; Su, Y.; Shao, N.; Yu, D.; Liu, Y.; Liu, W.; Zhang, Z. Luffa sponge-derived hierarchical meso/macroporous boron nitride fibers as superior sorbents for heavy metal sequestration. J. Hazard. Mater. 2019, 378, 120669. [Google Scholar] [CrossRef]
- Altınışık, A.; Gür, E.; Seki, Y. A natural sorbent, Luffa cylindrica for the removal of a model basic dye. J. Hazard Mater 2010, 179, 658–664. [Google Scholar] [CrossRef] [PubMed]
- Iqbal, M.; Edyvean, R. Alginate coated loofa sponge discs for the removal of cadmium from aqueous solutions. Biotechnol. Lett. 2004, 26, 165–169. [Google Scholar] [CrossRef]
- Liu, Z.; Pan, Y.; Shi, K.; Wang, W.; Peng, C.; Li, W.; Sha, D.; Wang, Z.; Ji, X. Preparation of hydrophilic luffa sponges and their water absorption performance. Carbohydr. Polym. 2016, 147, 178–187. [Google Scholar] [CrossRef] [PubMed]
- Hideno, A.; Ogbonna, J.C.; Aoyagi, H.; Tanaka, H. Acetylation of loofa (Luffa cylindrica) sponge as immobilization carrier for bioprocesses involving cellulase. J. Biosci. Bioeng. 2007, 103, 311–317. [Google Scholar] [CrossRef] [PubMed]
- Do, T.T.; Tran, L.V.; Bui, T.K.V.; Nguyen, T.Q. Research on the Application of Natural Materials as Biological Carriers in Wastewater Treatment for Beer Industry Using MBBR Technology; Scientific Research Report; Thuy Loi University: Hanoi, Vietnam, 2016. (In Vietnamese) [Google Scholar]
- Panneerdhass, R.; Gnanavelbabu, A.; Rajkumar, K. Mechanical properties of luffa fiber and ground nut reinforced epoxy polymer hybrid composites. Procedia Eng. 2014, 97, 2042–2051. [Google Scholar] [CrossRef]
- Rice, E.W.; Baird, R.B.; Eaton, A.D.; Clesceri, L.S. Standard Methods for the Examination of Water and Wastewater; American Public Health Association: Washington, DC, USA, 2012. [Google Scholar]
- Muyzer, G.; De Waal, E.C.; Uitterlinden, A.G. Profiling of complex microbial populations by denaturing gradient gel electrophoresis analysis of polymerase chain reaction-amplified genes coding for 16S rRNA. Appl. Environ. Microbiol. 1993, 59, 695–700. [Google Scholar] [CrossRef] [PubMed]
- Schwieger, F.; Tebbe, C.C. A new approach to utilize PCR–single-strand-conformation polymorphism for 16S rRNA gene-based microbial community analysis. Appl. Environ. Microbiol. 1998, 64, 4870–4876. [Google Scholar] [CrossRef] [PubMed]
- Yuan, Q.; Wang, H.; Hang, Q.; Deng, Y.; Liu, K.; Li, C.; Zheng, S. Comparison of the MBBR denitrification carriers for advanced nitrogen removal of wastewater treatment plant effluent. Environ. Sci. Pollut. Res. 2015, 22, 13970–13979. [Google Scholar] [CrossRef] [PubMed]
- The Ministry of Natural Resources and Environment. QVCN40:2011/BTNMT: National Technical Regulation on Industrial Wastewater (In Vietnamese); MONRE: Cầu Giấy, Vietnam, 2011.
- Martín-Pascual, J.; López-López, C.; Cerdá, A.; Gonzaález-Loópez, J.; Hontoria, E.; Poyatos, J.M. Comparative Kinetic Study of Carrier Type in a Moving Bed System Applied to Organic Matter Removal in Urban Wastewater Treatment. Water Air Soil Pollut. 2012, 223, 1699–1712. [Google Scholar] [CrossRef]
- Barwal, A.; Chaudhary, R. To study the performance of biocarriers in moving bed biofilm reactor (MBBR) technology and kinetics of biofilm for retrofitting the existing aerobic treatment systems: A review. Rev. Environ. Sci. Bio. 2014, 13, 285–299. [Google Scholar] [CrossRef]
- Im, J.-H.; Woo, H.-J.; Choi, M.-W.; Han, K.-B.; Kim, C.-W. Simultaneous organic and nitrogen removal from municipal landfill leachate using an anaerobic-aerobic system. Water Res. 2001, 35, 2403–2410. [Google Scholar] [CrossRef]
- Sánchez, E.; Borja, R.; Travieso, L.; Martín, A.; Colmenarejo, M.F. Effect of organic loading rate on the stability, operational parameters and performance of a secondary upflow anaerobic sludge bed reactor treating piggery waste. Bioresour. Technol. 2005, 96, 335–344. [Google Scholar] [CrossRef]
- Yoshino, Y.; Nakazawa, S.; Otani, S.; Sekizuka, E.; Ota, Y. Nosocomial bacteremia due to Kluyvera cryocrescens: Case report and literature review. IDCases 2016, 4, 24–26. [Google Scholar] [CrossRef] [PubMed]
- Iyer, R.; Iken, B.; Damania, A. Whole genome of Klebsiella aerogenes PX01 isolated from San Jacinto River sediment west of Baytown, Texas reveals the presence of multiple antibiotic resistance determinants and mobile genetic elements. Genom. Data 2017, 14, 7–9. [Google Scholar] [CrossRef] [PubMed]
- Vishnivetskaya, T.A.; Kathariou, S.; Tiedje, J.M. The Exiguobacterium genus: Biodiversity and biogeography. Extremophiles 2009, 13, 541–555. [Google Scholar] [CrossRef] [PubMed]
- Kulshreshtha, N.M.; Kumar, A.; Dhall, P.; Gupta, S.; Bisht, G.; Pasha, S.; Kumar, R. Neutralization of alkaline industrial wastewaters using Exiguobacterium sp. Int. Biodeter. Biodegr. 2010, 64, 191–196. [Google Scholar] [CrossRef]
- Taguchi, M.S.; Hanai, Y. New Wastewater treatment solution using Bacillus. Fuji Electr. Rev. 2017, 63, 54–59. [Google Scholar]
- Dastager, S.G.; Mawlankar, R.; Sonalkar, V.V.; Thorat, M.N.; Mual, P.; Verma, A.; Krishnamurthi, S.; Tang, S.-K.; Li, W.-J. Exiguobacterium enclense sp. nov., isolated from sediment. Int. J. Syst. Evol. Micr. 2015, 65, 1611–1616. [Google Scholar] [CrossRef] [PubMed]
- Poffe, R.; de Beeck, E.O. Enumeration of Aeromonas hydrophila from domestic wastewater treatment plants and surface waters. J. Appl. Bacteriol. 1991, 71, 366–370. [Google Scholar] [CrossRef] [PubMed]
- Azizi, S.; Valipour, A.; Sithebe, T. Evaluation of different wastewater treatment processes and development of a modified attached growth bioreactor as a decentralized approach for small communities. Sci. World J. 2013, 2013, 156870. [Google Scholar] [CrossRef] [PubMed]
- Grimont, F.; Grimont, P.A. The genus enterobacter. In The Prokaryotes; Dworkin, M., Falkow, S., Eds.; Springer: New York, NY, USA, 2006; Volume 6, pp. 197–214. [Google Scholar]
- Abbas, S.Z.; Rafatullah, M.; Ismail, N.; Lalung, J. Isolation, identification, characterization, and evaluation of cadmium removal capacity of Enterobacter species. J. Basic Microbiol. 2014, 54, 1279–1287. [Google Scholar] [CrossRef] [PubMed]
- Varghese, R. Bioaccumulation of cadmium by Pseudomonas sp. isolated from metal polluted industrial region. Environ. Res. Eng. Manag. J. 2012, 61, 58–64. [Google Scholar] [CrossRef][Green Version]
- Hoang, V.; Delatolla, R.; Abujamel, T.; Mottawea, W.; Gadbois, A.; Laflamme, E.; Stintzi, A. Nitrifying moving bed biofilm reactor (MBBR) biofilm and biomass response to long term exposure to 1 C. Water Res. 2014, 49, 215–224. [Google Scholar] [CrossRef] [PubMed]

| Treatment Compartment | Parameters | Value |
|---|---|---|
| Anoxic compartment | Wet dimensions, L × W × H (m) | 0.4 × 0.4 × 0.7 |
| Water volume (m3) | 0.112 | |
| Hydraulic retention time (h) | 2.65 | |
| Aerobic compartment (MBBR) | Wet dimensions L × W × H (m) | 0.4 × 0.8 × 0.7 |
| Hydraulic retention time (h) | 5.3 | |
| Water volume (m3) | 0.224 | |
| Circulation rate, R | 0.5Q | |
| Carrier filling rate | 30%V | |
| Air supply (m3 min−3) | 0.1 | |
| Sedimentation compartment | Wet dimensions, L × W × H (m) | 0.4 × 0.4 × 0.7 |
| Sludge circulation rate, Rb | 0.5Q |
| Parameters | Pristine Samples | Modified Samples |
|---|---|---|
| Material Size (mm) | 30–50 | 30–50 |
| Density (g cm−3) | 0.25 | 0.26 |
| Specific Carrier Filling ratio (%) | 87.5% ± 3% | 82.5% ± 3% |
| BET surface area (m2 g−1) | 0.018 | 0.875 |
| Operational Time (Day) | In Oxic Tank of Kim Lien Wwtp (CFU mL−1) | In Ifas with Modified Loofah Sponges (CFU mL−1) | On Modified Loofah Sponges within the IFAS (CFU gr−1) | On Pristine Modified Loofah Sponges (CFU gr−1) |
|---|---|---|---|---|
| 0 | 2.6 × 105 | 1.6 × 104 | 6.7 × 105 | 5.33 × 105 |
| 2 | 5.2 × 105 | 5.0 × 104 | 16.9 × 105 | |
| 6 | 6.7 × 105 | 25.5 × 104 | 187.0 × 105 | |
| 12 | 14.1 × 105 | 129.0 × 104 | 290.0 × 105 | |
| 24 | 22.8 × 105 | 3.92 × 104 | 11.3 × 105 |
| Groups | Name of Microorganism Strains | % Identity | E-Value * |
|---|---|---|---|
| 5.2M2 | Klebsiella aerogenes | 98.00% | 2e-92 |
| 5.2M4 | Exiguobacterium indicum | 99.00% | 7e-96 |
| 5.1M5 | Bacillus tropicus | 99.00% | 7e-96 |
| 4C4 | Aeromonas hydrophila | 100% | 3e-99 |
| 5.1M1 | Enterobacter mori | 98.97% | 7e-96 |
| 5.3C1 | Enterobacter cloacae | 100% | 3e-99 |
| 4C1 | Pseudomonas turukhanskensis | 99.48% | 2e-97 |
© 2020 by the authors. Licensee MDPI, Basel, Switzerland. This article is an open access article distributed under the terms and conditions of the Creative Commons Attribution (CC BY) license (http://creativecommons.org/licenses/by/4.0/).
Share and Cite
Dang, H.T.T.; Dinh, C.V.; Nguyen, K.M.; Tran, N.T.H.; Pham, T.T.; Narbaitz, R.M. Loofah Sponges as Bio-Carriers in a Pilot-Scale Integrated Fixed-Film Activated Sludge System for Municipal Wastewater Treatment. Sustainability 2020, 12, 4758. https://doi.org/10.3390/su12114758
Dang HTT, Dinh CV, Nguyen KM, Tran NTH, Pham TT, Narbaitz RM. Loofah Sponges as Bio-Carriers in a Pilot-Scale Integrated Fixed-Film Activated Sludge System for Municipal Wastewater Treatment. Sustainability. 2020; 12(11):4758. https://doi.org/10.3390/su12114758
Chicago/Turabian StyleDang, Huyen T.T., Cuong V. Dinh, Khai M. Nguyen, Nga T.H. Tran, Thuy T. Pham, and Roberto M. Narbaitz. 2020. "Loofah Sponges as Bio-Carriers in a Pilot-Scale Integrated Fixed-Film Activated Sludge System for Municipal Wastewater Treatment" Sustainability 12, no. 11: 4758. https://doi.org/10.3390/su12114758
APA StyleDang, H. T. T., Dinh, C. V., Nguyen, K. M., Tran, N. T. H., Pham, T. T., & Narbaitz, R. M. (2020). Loofah Sponges as Bio-Carriers in a Pilot-Scale Integrated Fixed-Film Activated Sludge System for Municipal Wastewater Treatment. Sustainability, 12(11), 4758. https://doi.org/10.3390/su12114758

